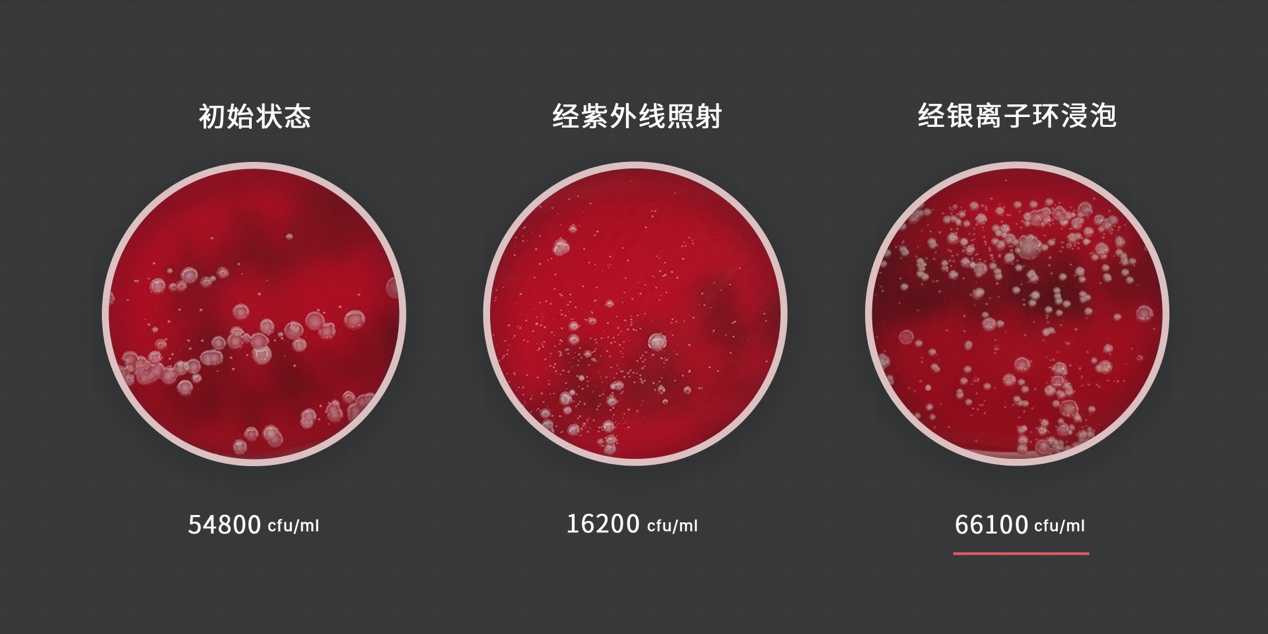
9成国人不会挑选加湿器：翻阅30万字论文，只为教你正确应对干燥

身在北方,你肯定对"空气干燥"不陌生,越来越多的家庭在意空气质量,越来越多的家庭使用加湿器缓解干燥。所以今天我们就通过问答的方式,彻底梳理,如何选择加湿器,加湿器对健康的影响,以及对应的该如何健康使用加湿器。
同时,我调研了30万字论文,发现有「干燥感」并不意味着家里湿度低,也可能是高湿度引发细菌滋生,再由细菌引起的「干燥感」错觉,这一点也会在文中详细论证。

本次对比评测的加湿器型号
我们从淘宝、京东、小米有品、网易严选这些电商平台,选择了热销以及有代表性的 10 款加湿器;并且从国内一流的实验室找来了气候箱,来做加湿性能的测试;同时,在北京市某著名大学附属三甲医院做了微生物检测。由于都是私人关系,这里就不方便透露他们的机构名了,毕竟以官方名义合作,要花不少钱。总之感谢两家匿名机构无偿对我们的支持。所有的这一切都是为了今天提供的观点科学和严谨。当然了,这些结果的呈现方式都尽量直观易懂的,很少用到晦涩的词汇,希望老少咸宜,毕竟用加湿器的人可没有年龄段划分。
全篇都是围绕"湿度"来讲解的,人们所说的湿度完整的说法叫"相对湿度",描述空气中的含水量。
我打赌,屏幕前超过90%的人不清楚自己房间的相对湿度。
人体舒适的相对湿度区间在40%~60%之间,高于60%,容易滋生细菌,墙面发霉。低于40%就容易感受到干燥。
想得到相对湿度,你需要一个湿度计,现在最新的技术可以做到这种带有数字显示的温湿度计,带有百分号的这里就是湿度了。

市面上常见的温湿度计
干燥空气带来诸多不适,也很容易被人们忽视。问了一圈身边的人,包括我自己,都早已习惯了北方的干燥。只能在每次舔到嘴唇上的干裂死皮的时候,才能意识到,自己一直是干燥的受害者。
加湿器最重要的是什么?
买加湿器中最重要的是看加湿量,也叫出雾量、蒸发量,都是一回事,用来描述机器加湿的能力,也就是每小时能向空气中输出多少毫升水分。
更大的加湿量,意味着能更快把环境加湿到舒适湿度,同时适用的空间面积也更大。建议在卧室中使用加湿量200 ml/h以上的加湿器,在通风的条件下,建议提高300 ml/h上;而客厅则需要更大的加湿量来维持湿度,500 ml/h或更高。总之,在其它条件相同的前提下,加湿量越大越好。

说明书中的加湿量
为什么市面上的加湿器测评鲜有提及加湿量?
因为他们不敢,就算提了,也不一定能信。加湿器的加湿量会受到环境影响,温度忽高忽低,湿度变来变去,那每次测得的结果就会不一样。要想严谨测得数据,必须要在可靠且稳定的恒温湿环境中,而这种环境在平时生活的环境中很难找到,了解到这一点的测评者,基本上就只聊聊相对湿度糊弄过去了,但相对湿度又跟温度息息相关,脱离温度讲湿度,是及不严谨的,因为这基本上没有对比的意义。
于是作为国内为数不多的独立测评机构,独立的从国内一流实验室中找来了气候箱,气候箱可以创造稳定的温度、湿度,是严禁的加湿量测量环境。可想要维持稳定的环境不是件容易的事,需要很多元器件持续精准的工作,所以它全功率运转每小时的用电成本就数百元。只有这样才能得到更详尽准确的测试结果,获得这些结果的过程很坎坷,好在结论是有价值的。

可以保持恒温恒湿的气候箱
以下是在恒温23℃、恒湿30%相对湿度的气候箱中测得的数据。
其中智米除菌型加湿器出雾量会根据湿度智能调节,在相对湿度低于30%时,出雾量会进一步提高。

实测加湿量
加风扇会不会提高加湿量?答案是会的。加风扇,不失为一个时临时提升加湿性能的办法,也更利于水汽扩散。

风扇可以提升蒸发型加湿器加湿量
除了加湿量,还包括了在接近家庭实际使用的环境中,测得的每一档噪音。

加湿器档位噪音与出雾量对照表
简单来说,蒸发型加湿器推荐Air X和巴慕达,超声波加湿器,分别适合卧室和客厅使用。
超声波型加湿器,推荐网易这款日式和风,适合在卧室使用。
毛巾+水盆的加湿效果怎么样?

毛巾+水盆
就这么说吧,毛巾+水盆,你以为这好比小米加步枪,实际上什么都不是,实验可以证明。
暖气加湿盒,原理本质与毛巾+水盆相同,但理论的加湿效率更高;在23℃的室内环境下,将它置于表面温度高达50℃的暖气片上。这几乎创造了"毛巾+水盆"最终极形态和最优势条件。实际测得的加湿量只有屈屈17.6 ml/h,几乎是性能垫底的京造加湿器的十分之一。

暖气加湿器
作为另一个对比,成年人每小时通过呼吸流失的水分就有25 ml [1],也就是说屋里多张嘴都比这东西管用。
毛巾+水盆真的"什么也不是",如果未来有考古学家发现我们毛巾+水盆,最多会认为这是装置艺术。
不要心存幻想。
真有不湿地板的加湿器吗?
真的有。严格的说,蒸发型加湿器,也就是无雾型加湿器,不会湿地板,因为它的原理类似于湿毛巾+风扇,挥发出直径仅仅 0.0004um的水蒸气,肉眼完全不可见,水蒸气扩散效率高。

水蒸气
而超声波型加湿器,借由震荡片将水打碎成直径1~5 μm的水珠,强行输出到空气中,形成浓浓的雾气。它的直径达到了水蒸气的2500倍,不易扩散,所以当周围瞬时相对湿度到达100%,雾气就会凝结成水滴,打湿地板。可以这样说:超声波型加湿器的加湿量越高越容易湿地板。
而且由于水雾直径过大,还会被PM2.5检测原件误判成污染物,和空气净化器离得近,就比较麻烦。
为什么有的超声波加湿器号称不湿地板,不能说人家虚假宣传,只能说出雾量太小了,水箱容量也很小,小到可能连合理的加湿能力都达不到。其实这种东西大多数会换一个名字叫"香薰机"。
自来水到底能不能用?
谣言害人,一知半解的科普更害人。
没错,水雾的确会让霾表误判 爆表,但这不是忽略污染物的理由。
自来水到底能不能用呢?这是个严肃的答案:蒸发型加湿器可以用;而不建议超声波加湿器使用自来水。
刚刚说过,超声波加湿器输出的水珠直径比较大,很容易携带直径比它小的污染物到空气中。而蒸发型加湿器挥发的水蒸气直径比较小,处在污染物直径区间的低位,不容易携带它们到空气里。

小水珠包裹着细菌
以北京为例,水中的固体物含量,达到200 mg/L,假设加湿器一周需要30 L,理论上就会溶解6 g固体物。这些粉状物,就是把30 L自来水风干后所得的,有时候呢加湿器附近的*粉白**也是它们。里面包含了直径很小的无机盐、重金属、还有细菌和病毒,无论是看起来还是闻起来都特别脏。

加湿器里的脏东西
有美国学者就针对"超声波加湿器 产生的污染物对于小鼠的肺部的影响" 进行过研究,确认了 超声波加湿器使用自来水会增加污染物浓度,同时发现了这些污染物造成小鼠肺部的异常反应。

超声波加湿器产生的污染物对于小鼠的肺部的影响
所以如果你现在家中正在用超声波加湿器,强烈建议使用更卫生的纯净水。
使用加湿器容易患病,是真的吗?
是真的,使用加湿器的家庭成员更容易患肺炎,儿童患湿疹、哮喘、过敏性鼻炎、哮喘的概率也均高于没有使用加湿器的家庭。
除了来自医生的经验分享,在一些调查中也有明确的结论。
内蒙古科技大学能源与环境学院、和 清华大学建筑技术科学系 的研究者,对包头市城区随机选取了5076名3~7岁儿童进行调查,发现,使用加湿器的家庭儿童"湿疹患病率"是不使用加湿器家庭的1.3倍。"(《住宅内加湿器使用对儿童湿疹患病率的影响》)

《住宅内加湿器使用对儿童湿疹患病率的影响》
另一项关于"加湿器与儿童过敏症状和疾病"的研究,对南京市的4014名1~8岁儿童进行了调查,发现"使用加湿器的家庭儿童患哮喘、鼻炎、过敏性鼻炎的概率均高于没有使用加湿器的家庭。" (《住宅室内空气品质感知和加湿器使用与儿童过敏性症状及疾病的关系》)

《住宅室内空气品质感知和加湿器使用与儿童过敏性症状及疾病的关系》
虽然得出这样的结论,但显然加湿器不能直接引起病症,两篇研究都把源头指向了水汽中的细菌。
要得到真相,就必须要弄清楚这些水里面到底发生了什么。为此我们专门找到了北京某知名大学三甲医院检验科室,进行了一次针对性的微生物检测,观察加湿器使用不同水源时,水中自然菌的生长情况。
大多加湿器的使用者,是懒惰的,机器中永远有残留旧水,几十年连绵不断,在明显察觉到水质变差之前,几乎不会清理。
家庭用水一共有三种 —— 自来水、白开水、纯净水。这哥仨在加湿器中残留的每一天,都在滋生细菌,一个星期之后,他们是这个样子的……

额…… 细菌是非常的微生物,所以无法凭肉眼观察到,要想用肉眼看到,需要来点特殊的方法 —— 细菌培养。
一次性真空采血管器是非常好的密封无菌容器,用来收集水样也再合适不过。整个实验过程中,我们使用一次性无菌医疗器械,将操作人员与样品隔离,避免任何环节对水样的污染。

一次性真空采血管器
收集好的液体会被送到检验科室,由专业人员将它们放到培养皿中。其中的营养成分为细菌繁殖提供充足的动力,这样每一个细菌都会迅速成长成肉眼可见的细菌团,通过计算细菌团的数量,可以间接得到细菌数量。经过一毫升定量接种,培养,一天后,结果出来了。你们猜猜自来水、白开水、纯净水,那种最脏?结果会令你吃惊。
残留一周后的纯净水,每毫升3700个菌落;自来水,54800个;你觉得多吗?……白开水,这已经多到数不清了,按照面积估算,每毫升至少10W+ 。

残留一周后的细菌声生长情况
这是他们一周前的样子。

意外吧,按理说高温杀菌后的白开水,细菌更少,似乎比较符合常常。但现实是白开水杀死的细菌尸体,为存活的细菌提供了营养物质,细菌在缺少竞争的环境中,疯狂繁殖,一周后的细菌数达到了残留自来水四倍以上,是残留纯净水的59倍。在另一项关于"水中自然菌生长情况"的调查中(《超声波加湿器内水中自然菌生长情况及其对空气污染的研究》),也出现了与我们实验一致的结果。
每毫升2W+到底是什么概念。我国《室内空气中细菌总数卫生标准》规定的室内空气细菌总数要<=4000 cfu/立方米。如果居住在15平方米的出租屋(15平40.5立方米,标准是162000个细菌),使用加湿量300的净化器(每分钟输出5 ml,10W+个细菌),不到半分钟,室内的细菌数就会超标,1小时候就会超标1800倍。这样的房间,你敢住吗。其它残水也不容乐观。
总而言之,永远不要使用残留的水来加湿。
除菌型加湿器能除菌吗?
有的能除菌。
市面上有两种主流除菌方式,"紫外线消毒灭菌",和"银离子环"除菌。原理它他们都是有效的杀菌方式,前提是在足够剂量的条件下——剂量足够大可以杀人,剂量太小就不好说了。
在这次所选的设备中,智米除菌加湿器采用了"紫外线消毒灭菌"方式,官宣"能杀掉98.8%细菌";Air X加湿器则的水箱中加入了银离子环,官方的宣传页中只说了抑菌,而没说杀菌,这有点意思。咱们就选这两台设备,来探究两种除菌方式的效果。
想要直观看除菌效果,又得奉上培养皿*法大**。
紫外杀掉了70%的细菌,银离子杀菌似乎是噱头
紫外杀掉了70%的细菌,虽然没有达到官方所宣称的98.8%杀菌效果,但客观的说,效果明显;
浸泡在银离子中的细菌,似乎完全无惧银离子的存在,继续生长着。
其实还有一种人工除菌方式,就是放加湿器消毒剂。但这种方式已经被证明使用不当会有生命危险。韩国在连续发生两百多起"加湿器消毒剂杀人案"后,已经全面禁售加湿器消毒剂,这种方法是千万不可采取的。
加湿器本身的除菌功能,也只能是作为辅助。要有效的降低水中微生物数量,办法只有一个:勤换水、勤清洗,长时间闲置的时候务必将废水倒掉,将水箱风干。
如何选择加湿器?
1. 无论有雾的超声波加湿器,还是无雾气蒸发型加湿器,你最需要关心加湿量,同等条件下,加湿量越大越好,即便多些冗余,也可以备不时之需。
2. 家庭加湿,蒸发型加湿器是最优选择。首先,它不会湿地板;其次而蒸发的加湿原理可以最大限度减小水中污染物进入空气的机会,更卫生;最重要的是蒸发型加湿器一般都具备风干功能,将残水风干,减小细菌滋生的机会。建议在同等加湿量的前提下,尽量选择噪音低的型号。
3. 安装净水器的家庭也可以选择超声波型加湿器,为了减轻湿地板的现象,优先选择具有恒湿功能的型号。
4. 在办公室使用,买个便宜的超声波加湿器就好了,水箱小点,接纯净水会比较方便,毕竟公司的纯净水免费又卫生。
为什么相对湿度很高了,依然感觉干燥?
我的湿度计都到60%了,为什么还是感觉干燥?我的湿度计坏了吗? 不,这事情可能比你想象的更严重。有这样感觉的人,不在少数。
住宅中出现霉点、湿点、凝结水汽这些明显的潮湿现象的家庭,感觉干燥的比例高于没有潮湿现象的家庭。其中出现霉点 —— 也就是严重潮湿现象的住宅中,感到干燥的人群比例高达62%。(《住宅室内空气品质感知和加湿器使用与儿童过敏性症状及疾病的关系》 《住宅室内环境对儿童哮喘的健康风险评估》 )

为什么会出现"空气越潮湿感觉越干燥"这么反常识的结果呢?
其实人体感觉到空气干燥的原因有两种:一种是室内空气相对湿度低造成的"物理性"干燥;另一种是由污染物造成的生理上的干燥感。
在节目开头说过,人体舒适的相对湿度在40%~60%之间,高于60%,的环境容易滋生细菌,再加上不良的加湿器用水习惯,长时间处于不卫生的高湿度环境中,生理上就会有类似干燥的症状。
至少62%加湿器用户,忽略了空气的实际湿度,在不良的空气环境造成的干燥感觉的情况下使用加湿器。家里常备一个湿度计看来很有必要的,如果家中"相对湿度很高了,依然感觉干燥",请务必关注空气卫生情况。
多项调查一致认为,室内人也的干燥感并不表明室内空气湿度低,而是通风不足造成的不良室内空气环境的一个很重要的信号。室内污染物使人产生了一系列干燥的症状,随着通风率的上升,室内人员的干燥感减弱。
综上所述,"相对湿度很高了,依然感觉干燥"是由于环境不卫生造成的。更健康的使用加湿器,务必要勤清洗水箱、用干净的水、同时要注意室内通风。
引用文献
●Sun Y,Zhang Y,Sundell J,et al. Dampness in dorm rooms and its associations with allergy and airways infections among college students in China:a cross-sectional study[J]. Indoor Air,2009, 9:348-356.
●Sundell J,Lindvall T. Indoor air humidity and sensation of dryness as risk indicators of SBS[J]. Indoor Air,1993, 3:382-390.
●Bakke JV,Levy F. Indoor air quality and climate in kindergartens – relation to health effects [C]. Proceedings of the 5th International Conference on Indoor Air Quality and Climate,Toronto,Canda. 1990, 1: 3-8
●Fang L,Wyon DP,Clausen G,et al. Impact of indoor air temperature and humidity in an office on perceived air quality,SBS symptoms and performance[J]. Indoor Air,2004,14:74-81.
●ZHENG Xiao-hong, SHEN Hong-ping, QIAN Hua, ZHAO Yi-li. Study on the perceived indoor air quality and use of humidifiers in residences and their association with allergies among children
●Masakazu Umezawa, Keisuke Sekita, Ken-ichiro Suzuki, Miyoko Kubo-Irie, Rikio Niki, Tomomi Ihara, Masao Sugamata, Ken Takeda, Effect of aerosol particles generated by ultrasonic humidifiers on the lung in mouse